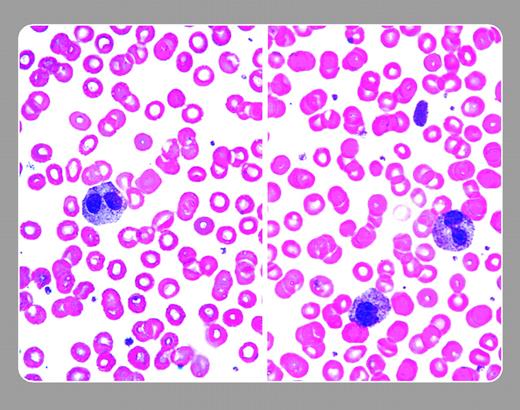
Figure 1. The lefthand blood smear is from a middle-aged male having laboratory testing for an annual physical examination. He had never been ill. The CBC was normal except for a report of increased number of bands. The bilobed polymorphonuclear leukocyte (poly) seen represented approximately 60% of his neutrophils. In 1928 Pelger described the inherited bilobed nuclear abnormality, and Huet reported it a few years later. This benign anomaly is associated with coarse nuclear chromatin and no functional cellular defects. The heterozygote expression of this autosomal dominant disorder (found in 1 of 6000 births) results in bilobed polys; the very rare homozygotic disorder shows monolobed polys. This patient needs no special attention. . / The righthand blood smear is from a patient with mild thrombocytosis. Note a similar bilobed poly as in Pelger-Huet, as well as a giant platelet. This bilobed poly was present in only a few of his white cells. Pseudo Pelger-Huet cells are acquired abnormalities commonly seen in hematology/oncology practice and are markers of underlying disorders, such as myelodys-plasia, myeloproliferative disease including acute leukemia, certain drugs, and occasional acute infections. This patient was diagnosed with essential thrombocythemia. . / Neil Abramson, Baptist Cancer Institute

The lefthand blood smear is from a middle-aged male having laboratory testing for an annual physical examination. He had never been ill. The CBC was normal except for a report of increased number of bands. The bilobed polymorphonuclear leukocyte (poly) seen represented approximately 60% of his neutrophils. In 1928 Pelger described the inherited bilobed nuclear abnormality, and Huet reported it a few years later. This benign anomaly is associated with coarse nuclear chromatin and no functional cellular defects. The heterozygote expression of this autosomal dominant disorder (found in 1 of 6000 births) results in bilobed polys; the very rare homozygotic disorder shows monolobed polys. This patient needs no special attention.
The righthand blood smear is from a patient with mild thrombocytosis. Note a similar bilobed poly as in Pelger-Huet, as well as a giant platelet. This bilobed poly was present in only a few of his white cells. Pseudo Pelger-Huet cells are acquired abnormalities commonly seen in hematology/oncology practice and are markers of underlying disorders, such as myelodys-plasia, myeloproliferative disease including acute leukemia, certain drugs, and occasional acute infections. This patient was diagnosed with essential thrombocythemia.
 Neil Abramson, Baptist Cancer Institute
Neil Abramson, Baptist Cancer Institute
The lefthand blood smear is from a middle-aged male having laboratory testing for an annual physical examination. He had never been ill. The CBC was normal except for a report of increased number of bands. The bilobed polymorphonuclear leukocyte (poly) seen represented approximately 60% of his neutrophils. In 1928 Pelger described the inherited bilobed nuclear abnormality, and Huet reported it a few years later. This benign anomaly is associated with coarse nuclear chromatin and no functional cellular defects. The heterozygote expression of this autosomal dominant disorder (found in 1 of 6000 births) results in bilobed polys; the very rare homozygotic disorder shows monolobed polys. This patient needs no special attention.
The righthand blood smear is from a patient with mild thrombocytosis. Note a similar bilobed poly as in Pelger-Huet, as well as a giant platelet. This bilobed poly was present in only a few of his white cells. Pseudo Pelger-Huet cells are acquired abnormalities commonly seen in hematology/oncology practice and are markers of underlying disorders, such as myelodys-plasia, myeloproliferative disease including acute leukemia, certain drugs, and occasional acute infections. This patient was diagnosed with essential thrombocythemia.
 Neil Abramson, Baptist Cancer Institute
Neil Abramson, Baptist Cancer Institute
Many Blood Work images are provided by the ASH IMAGE BANK, a reference and teaching tool that is continually updated with new atlas images and images of case studies. For more information or to contribute to the Image Bank, visit www.ashimagebank.org.

This feature is available to Subscribers Only
Sign In or Create an Account Close Modal